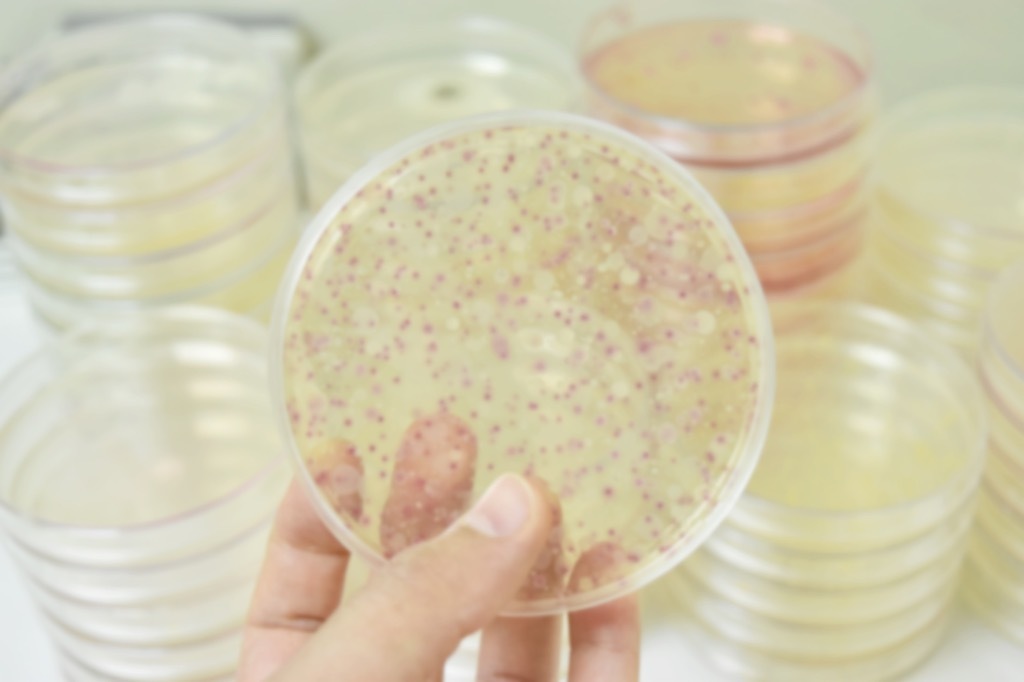
Bacteria Astonishing Facts

30 erstaunliche Fakten, die Sie dazu bringen, alles zu bezweifeln
Ist nichts wahr?
Haben Sie jemals das Aussehen des Wunders und des Erstaunens auf dem Gesicht eines Kindes gesehen, als sie gerade etwas Bemerkenswerter von der Welt gelernt haben, und ihr Geist wurde geblasen? Als Erwachsene werden wir zu oft mit unserem Wissen selbstgefällig. Wir denken, wir sind zu alt, um leicht beeindruckt zu sein oder die Freizeit mehr zu haben, um neugierig zu sein und Dinge zu entdecken, die wir nie in der Schule gelernt haben. Es gibt jedoch immer mehr Gehirn-wickelende Tatsachen, die Ihren Kiefer wie ein Kind fällt, das gerade über die Schwerkraft gelernt wird.
Wussten Sie zum Beispiel, dass die Mona-Lisa im Badezimmer des französischen Monarchen hängt? Oder dass die Art und Weise, wie Buchstaben im Alphabet organisiert sind, völlig zufällig? Oder dass Fergie der Popgruppe die Black Eyed Erbsen war derStimme der Schwester von Charlie Brown Sally während der Mitte der '80er Jahre? Sie wussten wahrscheinlich nicht mindestens eines dieser Dinge. Und wenn Sie es getan haben, haben wir viele Faktoide, woher diese kamen. Hier finden Sie 30 erstaunliche Fakten, die daran erinnern, was es anfühlt, sich wieder ein Kind zu sein. Mit anderen Worten, Sie werden alles fragen. Und für mehr lebensänderende trivia stecken Sie die30 Erstaunliche Tatsachen, die die Welt ändern, wie Sie die Welt sehen.
1 Wir haben weniger als fünf Prozent des Ozeans erforscht.

Es gibt mehr Meer als Land auf unserem Planeten; Der Ozean deckt tatsächlich mehr als 70 Prozent der Erdoberfläche ab. Aber Menschenmüssen noch 95 Prozent davon erkunden. Was könnte da unten sein? Wer weiß? Vielleicht werden einige zukünftige Jacques Costau herausfinden. Und für wilde Infos über diesen dritten Rock von der Sonne, überprüfen Sie diese30 verrückteste Fakten über Planetenerde, die Sie nie wussten.
2 Sie haben noch nie Ihre eigenen Augen gesehen, nur Reflexionen von ihnen.

Es sei denn, Sie haben einen Ihrer Augen wie den Charakter in einer griechischen Tragödie geputet, haben Sie nie Ihre eigenen Augen gesehen. Sie haben Reflexionen von ihnen in Bildern oder Spiegeln gesehen, ja, aber das ist dabei. Wir fangen nur flüchtige Einblicke unserer Nasen und Lippen, aber unsere Augen, die für unsere Persönlichkeiten so grundlegend sind, sind wir nur, dass wir nur Secondhand erleben.
3 Ein japanischer Mann überlebte sowohl die Hiroshima als auch die Nagasaki-Atombombenanschläge und lebte als 93.

Er war ein 29-jähriger Naval-Ingenieur auf einer Geschäftsreise nach Hiroshima, als die erste Bombe fiel. Er kam gerade rechtzeitig nach Nagasaki für die zweite Bombe nach Hause. Es ist bemerkenswert, dass Tsutomu Yamaguchi in einem dieser atomaren Explosionen nicht vergrößert hat, und es ist noch bemerkenswerter, dass er irgendwie weitere 65 Jahre lang lebte, bevor er in seinen frühen 90er Jahren an Bauchkrebs sterbsen. Schauen Sie sich diese an, um weitere Lebensunterricht zu überprüfen50 grundlegende Fakten über das Leben, das jeder wissen sollte.
Bild über Wikimedia Commons
4 Es gibt mehr Möglichkeiten, ein Kartenspiel zu mischen, als es Sterne am Himmel gibt.

Es gibt rund 100 Milliarden Sterne, was viel erscheint. Aber es ist nichts im Vergleich zu dem, was Sie mit einem Deck von 52 Karten tun können. TeducatorYannay Khaikin. Ansprüche Es gibt 80.000.000.000.000.000.000.000.000.000 000 000 000 000 000 000 000 000 000 000 000 000 000 000 000 000 000 000 000 000 000 000.000 (für die zähigkeit-averse: das sind 67 Nullen) verschiedene Wege, um ein Kartenspiel zu ordnen, und das könnte eine geringe Schätzung sein. "Jedes Mal, wenn Sie ein gut mischtes Deck aufnehmen, halten Sie fast sicher eine Anordnung von Karten, die noch nie zuvor existiert, und möglicherweise nicht mehr existieren", sagt er.
5 Die 50-Sterne-amerikanische Flagge wurde von einem Highschool-Studenten entworfen, der einen B-.

Ohio Teenager Robert Heft entworfen Amerikas aktuelle Flagge für ein High-School-Geschichtsklasse-Projekt. Sein Lehrer war unimprimiert und gab ihm ein B-, aber versprach eine bessere Note, wenn er irgendwie seine Flagge vom Kongress angenommen hatte. "Viel Glück damit, Kind. Oh, warte!" Und für wertvollere Schulunterricht prüfen Sie diese20 United States Civic Studies-Lektionen, die Sie vergessen haben.
6 Saudi-Arabien importiert Sand und Kamele aus Australien.

Mehr als die Hälfte der Geographie von Saudi-Arabien ist die Wüste, aber der ganze glatte Sand macht sie nicht viel gut für den Bau, wo sie am meisten Sand benötigen. Australiens Granatsand ist die ideale Qualität für Sandstrahlen und für Materialien wie Farbe und Zement. Wie für Kamele gelten die wilden Kamele Australiens als Delikatesse in Saudi-Arabien, in der die Kamelbevölkerung von Krankheiten, Dürre und politischer Instabilität dezimiert wurde. Ja, Saudis essen Kamele wie Amerikaner essen Cheeseburger.
7 Die Oxford University ist älter als das Aztekreich.

Als Oxford als älteste Universität in der englischsprachigen Welt beschrieben wird, ist es schwer, nur alt zu ergründen, das ist. Wir reden nicht alt in Amerikanischen Begriffen, wo ein paar hundert Jahre für immer anscheinend erscheint. Die Oxford wurde vor dem Jahr 1096 fast ein Jahrtausend gegründet. Der Aztec-Stadtstaat von Tenochtitlan wurde 1325 gegründet. Das heißt, die Universität, die Stephen Hawking, Oscar Wilde, und 27 britische Premierminister 200 Jahre alt sindälter als das Aztekreich. Und um mehr Möglichkeiten, Ihr Trivia-Nachtspiel zu steigern, überprüfen Sie diese30 verrückte Fakten über das Leben, das Sie ein wenig ausflippen kann.
8 Vierjährige Mädchen stellen einen Durchschnitt von 390 Fragen pro Tag.

Dies ist laut einem Bericht des EinzelhändlersLittlewoods, ist nur die durchschnittliche Anzahl der Fragen vierjähriger Mädchen fragen. Dies bedeutet, dass Eltern und Lehrer diese Fragen alle eine Minute und 56 Sekunden ihrer Wachzeiten beantworten. Am anderen Ende des gesprächigen Spektrums fragen neunjährige Jungs durchschnittlich 144 Fragen pro Tag. Was in ganz Ehrlichkeit immer noch eine schwere Dosis Neugier erscheint.
9 Die Google-Gründer versuchten, ihr Unternehmen für 750.000 US-Dollar zu verkaufen.

Im Jahr 1999, als Google immer noch ein Startup als Startup betrachtet wurde, versuchten die Gründer Larry-Seite und Sergey Brin, ihr Unternehmen auf Anregung zu entladen, eines der ursprünglichen Internetportale. Sie boten ursprünglich 1 Million US-Dollar und wurden auf 750.000 US-Dollar gesprochen, aber der Erregung verging. Sie treten wahrscheinlich immer noch immer noch selbst, wie heute die Marke schätzungsweise 120,9 Milliarden US-Dollar wert ist. Und um mehr über den allgegenwärtigen E-Riese, überprüfen Sie die15 Dinge, die Sie definitiv nicht von Google wussten.
10 Einmal im Jahr regnet der Himmel mit Fischen in Honduras.

In Yoro ist Honduras, das Leben schwer. Die meisten seiner 93.000 Einwohner leben in Armut - außer dass ein besonderer Tag des Jahres der Himmel mit Fisch regnet. Dieser Rain of Fish oder als die Einheimischen nennen es, "Lluvia de Peces", passiert einmal im Jahr während einer strömenden Rockpour, die die Stunden dauern kann. Nachdem der Regen klar ist, kommen Einheimische aus ihren Häusern, um den Hunderten von Fischen zu sammeln, die auf dem Boden zerstreuten.Nationale Geographie Schickte ein Team, um dieses Phänomen in den 1970er Jahren zu untersuchen. Während sieBestätigt Dass das Ereignis tatsächlich stattfindet, konnten sie nie angeben, warum und wie es eigentlich tut.
11 Die Wahrscheinlichkeit, dass Sie das gleiche Wasser verbraucht haben, da Cleopatra 100 Prozent beträgt.

Es gibt kein "neues Wasser". Wir trinken im Wesentlichen das gleiche Wasser, das andere Menschen vor über 2.000 Jahren genossen hat. Das heißt in einem bestimmten Glas H2O,Wissenschaftler schätzen. dass es mindestens ein Molekül gibt, das in demselben Wasser gefunden wird, das Cleopatra sättigte. Herzlichen Glückwunsch, Sie haben gerade einen Spieß mit einer toten ägyptischen Königin ausgetauscht.
12 Unsere Körper haben mehr Bakterien als menschliche Zellen.
Der menschliche Körper hat ungefähr 30 Billionenzellen darin. Es hat auch ungefähr 39 Billionenbakteriell.Zellen. Das bedeutet, dass Ihr Körper mehr Bakterien ist als der Mensch. Das ist kein städtischer Mythos, es ist gewesenmit der Wissenschaft nachgewiesen. Die menschliche Zelle zu Bakterienverhältnis ist 1: 1.3 und die Bakterien sindgewinnend. Es gibt hier irgendwo ein Zombie-Witz, aber wir sind zu schwindlig von allen Bakterien in unseren Körpern, um daran zu denken.
13 Es gibt dreimal so viele Hühner wie Menschen.

Von allen Tieren, die Sie besorgt haben, könnten uns überlümmelten, Sie haben wahrscheinlich nie vermutet, dass Hühner einen Vorteil haben würden. Aber es ist wahr! Nach Angaben der globalen Nutzung der Vereinten Nationen der Vereinten Nationen sind 19 Milliarden Hühner die Erde bewohnen. Zum Vergleich gibt es nur etwa 7,4 Milliarden Menschen. Sie haben uns überlastetdrei zu eins. Und wir essen ihre Eier! Jedes Mal, wenn Sie einen offen knacken, versuchen Sie, nicht darüber nachzudenken, dass die Hühnerbevölkerung wächst, und jemand, den sie für Rache kommen könnten.
14 Wenn Schallwellen durch den Raum zurückgeführt werden, wäre die Sonne lauter als eine Kettensäge.

Die Sonne ist ungefähr 92,96 Millionen Meilen von uns entfernt, aber es ist auch ein riesiger Kugel des brennenden Plasmas mit Temperaturen, die 27 Millionen Grad Fahrenheit erreichen. Wenn dieser Sound irgendwie durch den Weltraum reisen konnte, schätzen Solar Astrophysicists die Solar-Astrophysiker, dass die Schallintensität um 100 Dezibel sein würde, was das Dezibel entspricht, der eine Kettensäge, einen Klinke oder einen Traktor entspricht. Aber das Geräusch würde niemals aufhören. Nach etwa acht Stunden dieses Dezibelbereichs wären wir alle taub.
15 In dem Ozean ist ein Müllwirbel, der Größe von Texas ist.

Dieser Wirbel, offiziell alsTolles Pazifik-Müll-Patch, befindet sich zwischen Hawaii und Kalifornien. Im Patch gibt es schätzungsweise 1,8 Billionen-Plastikstücke, die zusammengeschlossen sind, um ungefähr 500 Jumbo-Jets zu wägen. Es wird wahrscheinlich nicht überraschen, dass all dieses Kunststoffs eine tödliche Wirkung auf Tierwelt in der Umgebung hat. Von jedem von dem Müllspiegel gesammelten Probe enthielt 84 Prozent giftige Chemikalien in Zugang.
16 Ureinwohner Amerikaner konnten bereits Englisch sprechen, bevor Sie die Pilger treffen.

Wie Sie wahrscheinlich (und hoffentlich) in der Geschichte der Geschichtsklasse gelernt haben, begannen Sie amerikanische Amerikaner Squanto, der Pawtuxet-Stamm, und Massasoit, der Chef des Wampanoag-Stammes, mit den Pilgern befreundet und half ihnen, zu überleben, als sie sich gegen den Zorn ihres Neuen ausgerüstet hatten Heimat. Squanto wurde während dieser Zeit der Übersetzer und ging zwischen den amerikanischen Ureinwohnern und Pilgern.
Allerdings dasGeschichte Wie Squanto lernte Englisch, ist das interessanteste, wenn nicht vernachlässigt, ein Teil der Geschichte. Ein Jahrzehnt, bevor er jemals auf den Pilgern traf, wurde Squanto von einem britischen Schiff gefangen genommen und in Spanien in Sklaverei verkauft. Er wurde von einem spanischen Mönch gekauft, der ihn gut behandelte und ihm Englisch lehrte. Dann arbeitete Squanto für John Slaney, der mit seinem Wunsch sympathisiert, nach Hause zu gehen, und schickte ihn letztendlich ein paar Jahre später nach Amerika zurück.
17 Es gibt 200 Leichen am Mount Everest.

Seit 1953 haben mehr als 4.000 Menschen versucht, diesen berühmten (oder berühmten) Gipfel zu skalieren. Viele haben es geschafft, und einige sind schon ein paar gestorben. Die Toten machen es nicht immer den Berg hinunter, vor allem, wenn sie über 26.000 Fuß abläuft, im oberen Teil von Everest, der als "Todzone" bekannt ist. Die berühmteste Leiche, bekannt als "grüne Stiefel" -A Spitzname, er bekam wegen seiner ausgeprägten grünen Stiefel, die 1996 gestorben war, und war ein familiärer Anblick, der auf der Haupt-Nordostrinne der nordöstlichen Ridge-Route auf dem hairen Nordost-Ridge-Route angeklagt wurde, bis sein Körper im Jahr 2014 entfernt wurde. Dort Möglicherweise hunderten mehr - die offizielle Schätzung ist 200 - und sie bleiben dort als grimmige Erinnerungen an Kletterer, die denkst, dass Everest zu leicht sein könnte, um sich zu erobern.
18 Jeder in allen 200 Männern am Leben hängt von Genghis Khan zusammen.

Ja, das stimmt, Fellas. Sie könnten mit dem legendären Legenden der Geschichte der Geschichte zusammenhängen. Ein internationales Team von Genetiker machte das ErstaunenEntdeckung Dass der Mongolführer mit demselben Y-Chromosom etwa 16 Millionen Männer in der Welt hat.
19 Mehr Menschen werden von Lawnmauer getötet als Haie.

Jedes Jahr werden durchschnittlich 69 Amerikaner von Lawnmwers getötet. Manchmal ist es ihre Rasenmäher oderdie Rasenmäher ihrer Elternoder Rasenmäher dasaus dem Himmel fliegen Während der Fußballspiele. Hai-Angriffe sind weit weniger üblich, mitNur fünf Leute Weltweit letztes Jahr von Sharks getötet.
20 Es gibt mehr öffentliche Bibliotheken in den USA als McDonalds und Starbuckskombiniert

Wenn Sie wie wir sind, haben Sie wahrscheinlich gegrolschnet, dass es an jeder Ecke Amerikas entweder ein McDonalds oder Starbucks gibt. Aber wir haben uns nie über alle Bibliotheken beklagt. Niemand hat jemals gesagt: "Oh nach Pete willen, eine andere Bibliothek öffnete sich in meiner Nachbarschaft. Haben wir nicht genug von diesen Dingen?" Aber da sich herausstellt, überlastet Bibliotheken beide mcdonaldsund Starbucks. Es gibt in den USA im Jahr 2018 eine erstaunliche 119.487 Arbeitsbibliotheken, und nur 14.146 McDonalds und 8.222 Starbucks. Denken Sie darüber nach, wenn Sie das nächste Mal pessimistisch in unserem Land fühlen: Es ist technisch einfacher, Kredite für das Darlehen als einen großen Mac zu finden.
21 J.P Morgan bot jeden, der ihm erzählen konnte, warum sein Gesicht so rot war.

J.P Morgan, ein äußerst erfolgreicher Banker und Finanzier im späten 19. und frühen 20. Jahrhundert, hatte alles Geld kaufen, außer einer Antwort auf den Grund, warum sein Gesicht so warrot. Er bot eine belohnte 100.000 US-Dollar für jeden, ärztliche Fachmann oder anderweitig an, der sein seltsames rotes Gesicht und seine riesige, violette Nase erklar oder heilen konnte. Niemand hatte einen Hinweis, und der rot gegenübergeordnete Morgan starb 1913, Jahre, bevor er den Zustand als Rhinophym diagnostiziert worden wäre.
22 Russland und Pluto sind ungefähr die gleiche Größe.

Sie müssen sich schlecht für Pluto fühlen. Es wurde 1930 endgültig entdeckt und wurde in unserem Sonnensystem als 9. Planet klassifiziert, nur um 2006 in den Zwergplanet herabgestuft zu werden, und dann (irgendwie) in den letzten Jahren (irgendwie) in den letzten Jahren als (Kinda) Planet wieder eingesetzt. PLUTOs öffentliches Image-Problem wurde nur noch schlimmer, als der kleine Planet-königte entschlossen war, eine Fläche von nur 16.647.940 Quadratkilometern zu haben - etwas kleiner als Russland, was 17.075.200 Quadratkilometer erstreckt. Dann schickte NASA die neue Horizonts-Sonde für einen genaueren Blick 2015, und stellte fest, dass Pluto ein winziges Bit größer war - um 0,1 Prozent, knapp über einem Meilen, der ihm einen leichten Vorteil gegenüber Russland gab. Es scheint wie ein Sieg, aber wenn ein verrückter Planet spielt, "Wer ist größer" mit einem Land auf einem viel größeren Planeten, ist es nur peinlich für alle. Es wäre wie ein 50-jähriger Mann, der mit einem Kleinkind, der größere Hosen hat, argumentiert.
23 Britische Teenager glauben an Sherlock Holmes mehr als Winston Churchill.

Laut einer Umfrage von 2008 waren 20 Prozent der britischen Teenageräte überzeugt, dass Winston Churchill, der Premierminister des Vereinigten Königreichs während des Zweiten Weltkriegs, ein fiktiver Charakter war. Noch deprimierender, ein erstaunlicher 58 Prozent von ihnen waren davon überzeugt, dass Sherlock Holmes eine echte Person war.
24 Wenn Sie Ihren Finger in Ihr Ohr legen und es wackeln, klingt es genau wie Pac-Man.

Es klingt dumm, aber Sie sollten es ernsthaft versuchen. Seien Sie bereit, die nächste Stunde damit zu verbringen, mit Ihren Freunden zu streiten, ob die Schöpfer von Pac-Man inspiriert wurden, indem er ihr Ohr kratzen oder wenn es nur ein bizarrer Zufall ist.
25 Alabama ist der einzige US-Staat mit Booze als offizielles Staatsgetränk.

Sie wählten Conecuh Ridge Whisky, einen 86-Beweis-Braun-Alkohol, der ursprünglich ein Verbot-Ära Moonshine war, als offizielles Alabama-Getränk im Jahr 2004. Der Whisky-Maker wurde dann auf Alkoholrechtsverletzungen geschlagen. Süßes Zuhause Alabama, tatsächlich.
26 Jousting ist der offizielle Sport von Maryland.

Maryland wurde der Erste als erster, der einen staatlichen Sport erkläre, als sie sich 1962 entschieden haben, Jousting von allen Dingen als ihre offizielle Erholung zu erlassen. Jousting ist seit der mittelalterlichen Ära in der Nähe, und Maryland hat seit der Kolonialzeit Turniere mit vielen der gleichen Praktiken und Kostüme angehalten.
27 Eichhörnchen pflanzen jedes Jahr Hunderte von neuen Bäumen.

Das Tolle an Eichhörnchen ist, dass sie lieben, Nüsse verstecken, und sie haben schreckliche Erinnerungen. Anscheinend findet das durchschnittliche Eichhörnchen nicht 74% der Nüsse, die sie begraben. Und einige dieser Nüsse, besonders wenn sie Eicheln sind, werden am Ende Baby-Eichen. Das nächste Mal, wenn Sie einen Eichenbaum sehen, bedanken Sie sich auf ein Eichhörnchen.
28 Mehr Menschen auf der Welt leiden an Fettleibigkeit als von Hunger.

In letzter Zeit haben Wissenschaftler eine Verschiebung in Richtung der Wölbung von Bäuche entdeckt - und vom Hunger weg. Die Internationale Föderation von Rotkreuz- und Rot-Crescent-Gesellschaftenerwähnt Dass etwa 1,5 Milliarden der Welt an Fettleibigkeit leidet, während nur 925 Millionen unterernährt werden. Diese Entwicklung ist jedoch sinnvoll, wenn Sie erkennen, dass wir, dass wir in den letzten 200 Jahren die Kunst der Lebensmittelproduktion beherrschen, dh wir sind eine Gesellschaft, die für höchstens niemals Hunger erleben wird.
29 Mars ist vollständig von Robotern bevölkert.

Es gibt keine Lebensformen auf dem Mars, es sei denn, Sie zählen Roboter. Seit 1997, als der Mars-Pathfinder erfolgreich auf dem roten Planeten landete, der einen Rädern Roboter Rover namens Sojourner sendet, um zu erobern ... Er meinen wirentdecken Der Planet-Mars wurde vollständig von Robotern bewohnt.
30 Die Arkansas-Schule für das Fußballmannschaft der Gehörlosen wird als Leoparden bezeichnet. Sie sind die tauben Leoparden.

Wenn Sie der Meinung sind, dass es sich um eine Zungen-in-Wangen-Referenz auf die Rock-Band def Leppard handelt, würden Sie falsch sein. Das Team wurde seit mindestens 1941 als taube Leoparden genannt. Überprüfen Sie diese30 Vornamen für Ihre Lieblingsbänder.
Um fantastische Geheimnisse zu entdecken, um Ihr bestes Leben zu leben,Klicke hierUm sich für unseren kostenlosen täglichen Newsletter anzumeldenSchnitte
60 hysterische "Anti-Jokes", wir können nicht aufhören zu lesen
Richard Simmons Beiträge zur Nachricht "Ich sterbe" - aber später sagt ihm, dass es ihm gut geht